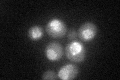
YKL205W
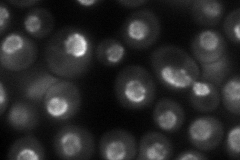
YKL205W

View description
Nuclear pore protein involved in nuclear export of pre-tRNA and in re-export of mature tRNAs after their retrograde import from the cytoplasm
Localization:
Intensity:
Fold change:
Significance:
-
C’ GFP library in SD
nuclear periphery37.88 -
N' NOP1pr-GFP in SD
punctate,nuclear periphery84.373 -
N' TEF2pr-mCherry in SD

punctate,nuclear periphery85.8631 -
N' NATIVEpr-GFP in SD

punctate,nuclear periphery83.0996 -
N' TEF2pr-VC and Cyto-VN in SD

#N/A0 -
C’ GFP library in SD+DTT

nuclear periphery28.760.75No -
C’ GFP library in SD+H2O2

nuclear periphery370.97No -
C’ GFP library in Starvation Media

nuclear periphery21.040.55Yes -
C’ GFP library on the background of Pup2-DaMP

nuclear periphery -
C’ GFP library on the background of CCT mutant

nuclear periphery44.05431.16265No
